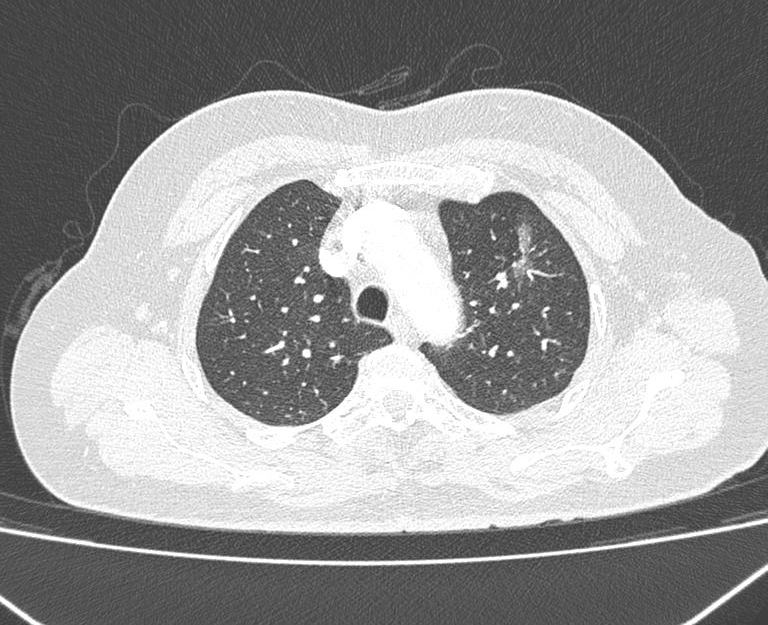
三年精准随访！黄山华泽医院肺结节诊治中心全力守护呼吸健康！

61 岁的张阿姨拿着病理报告,脸上露出了久违的笑容。
时间回到 2022 年,当 58 岁的张阿姨在常规体检中,意外发现左上肺存在一枚肺结节。忧心忡忡的她立刻前往外院就诊,胸外科医生通过读片判断,这枚结节大概率是早期肺癌,建议她立即接受手术治疗。突如其来的 「坏消息」 让张阿姨慌了神,「当时一听说可能是癌症,我脑子都乱了,总觉得手术是大事,想多找专家问问情况。」张阿姨了解到黄山华泽医院常务副院长、呼吸与危重症医学科主任医师陈新民在肺结节诊疗方面有丰富经验,便带着所有检查资料前往咨询。陈新民副院长仔细询问病史、反复研读胸部 CT 影像后,结合临床经验给出专业判断:这枚结节属于纯磨玻璃结节,边界清晰,虽直径已超 2 cm,但首次发现且无明显恶性特征,即便为恶性,短期内也不会快速进展。「考虑到您年龄不算大,既要保障生命周期,也要不影响正常工作生活,目前更适合 3-6 个月定期复查,动态观察结节变化。」陈院长的耐心解释,让焦虑的张阿姨渐渐安下心来。
2023 年 1 月

2023 年 8 月

2024 年 5 月

此后三年,张阿姨严格遵循陈院长的诊疗建议,定期复查。每一次 CT 检查后,陈院长都会细致对比结节的大小、密度、形态,为她建立专属的诊疗档案。
转折发生在 2025 年 6 月份的随访中。陈院长在对比最新 CT 影像时发现,张阿姨的肺结节出现了明显变化:直径增大、密度增高,不仅出现近 20% 的实性成分,还伴随分叶、毛刺、血管集束征、空泡等典型恶性肿瘤特征。同时,医院肺结节 AI 诊断系统也提示 「恶性可能性大」。「结节已经到了需要干预的时机,不过您别担心,我们会尽快组织多学科专家会诊,制定最适合您的方案。」 陈院长第一时间将情况告知张阿姨,并立即启动医院肺结节诊治中心的多学科协作(MDT)机制。
2025 年 6 月
很快,一场由陈新民副院长、胸心外科朱金美副院长、汪涛主任、影像科高磊主任、病理科汪露祥主任等多位专家组成的会诊正式召开。专家们围绕张阿姨三年来的影像资料、结节变化趋势、AI 诊断结果展开深入讨论,最终达成一致意见:结节符合早期肺癌特征,建议尽快实施微创手术治疗,有望有效切除病灶,同时最大程度保留肺功能。


看到专家们严谨的分析、专业的建议,以及医护人员热情的服务,张阿姨和家属彻底打消了顾虑,当即决定住院手术。入住胸外科后,朱金美副院长团队并未急于手术,而是针对结节位置偏深的特点,再次组织全科讨论,最终确定采用 「左上肺前段切除」 方案,并利用 3D 重建技术精准规划手术路径,确保在彻底清除病灶的同时,减少对正常肺组织的损伤。
7 月份,手术如期进行。朱金美副院长带领团队,采用单孔胸腔镜技术,仅在张阿姨腋下切开约 3 cm 的微小切口,便顺利完成了左上肺前段切除手术。术中冰冻切片报告显示为 「原位腺癌」,与术前诊断完全一致。术后第二天,张阿姨就能下床正常活动;复查胸片显示肺部复张良好;术后第五天,她便顺利出院,开启了康复生活。


更让张阿姨安心的是,最终病理报告明确显示:(左上叶)肺原位腺癌长径 2.0 cm,肺被膜和闭合端切缘无病变累及,12 枚送检淋巴结均未发现癌转移。这意味着,通过及时的微创手术,她的肺癌得到了有效控制,达到临床治愈标准,术后无需进行放化疗,只需定期复查即可。

张阿姨的经历,正是黄山华泽医院肺结节诊治中心规范诊疗的生动缩影。该中心依托多学科协作模式,整合呼吸科、胸外科、影像科、病理科等优势资源,针对不同类型的肺结节制定 个体化诊疗方案—— 对于良性或低风险结节,采用定期随访动态观察,避免过度医疗,实现 「早发现、早诊断、早治疗」 的诊疗目标,为广大肺结节患者守护呼吸健康。
好文章,需要你的鼓励
















